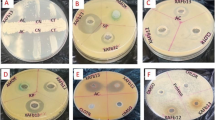

Abstract
Viola odorata, a medicinal plant, is traditionally used to treat common cold, congestion and cough. Given its medicinal properties and occurrence in the northwestern Himalayas, we isolated and characterized endophytic fungi from this plant morphologically, microscopically and by internal transcribed spacer-based rDNA sequencing. In total, we isolated 27 morphotypes of endophytes belonging to phyla Ascomycota and Basidiomycota. The roots showed the highest diversity of endophyte as well as fungal dominance, followed by leaves and leaf nodes. The fungal extract of VOR16 (Fusarium oxysporum) displayed potent antimicrobial activity against Salmonella typhimurium, Klebsiella pneumoniae and Escherichia coli, with a minimum inhibitory concentration of 0.78, 0.78 and 1.56 μg/mL, respectively, while fungal extract VOLF4 (Aspergillus sp.) exhibited promising antioxidant activity (IC50 of 17.4 μg/mL). To identify the components responsible for various bioactivities, we analyzed the content of penicillin G in the extract of bioactive endophytes. The results suggested that the expression of penicillin G under the fermentation conditions applied was too low to display antimicrobial effects. Thus, the activity may be contributed by a different, novel secondary metabolite. The antioxidant activity of VOLF4 may be attributed to its high content of flavonoids. Of the endophytic fungi assessed, 27% were found to be enzyme producers. The highest zone of clearance was observed in VOLN5 (Colletotrichum siamense) for protease production. Only VOR5 (Fusarium nematophilum) was found to be a producer of cellulase, glutenase, amylase and protease. In summary, this is the first report of the isolation of endophytes, namely Fusarium nematophilum, Colletotrichum trifolii, C. destructivum, C. siamense and Peniophora sp., from V. odorata and their bioactive and enzyme-producing potential.
Similar content being viewed by others
Introduction
Endophytes are organisms, often fungi and bacteria, that reside healthy plant tissues without causing any deleterious effects (Strobel and Daisy 2003), exhibiting a variety of interactions with the host that range from mutulistic to antagonistic (Clay and Holah 1999). They occur in all plants on earth, suggesting that they are involved directly or indirectly in the growth, fitness, ecology and evolution of the plant (Brundrett 2006; Vega et al. 2010). The endophytic community varies plant to plant and is affected by a variety of factors, such as environment, season, cultivar, among others (Kaul et al. 2012; Martins et al. 2016). Endophytes also profoundly influence the community structure and diversity of the host-associated organisms, such as bacteria, nematodes and insects (Omacini et al. 2001). Thus, it is imperative to study the endophytic community of a plant inhabiting a particular ecological niche.
Endophytes are a rich source of bioactive natural products, which are currently used in agriculture, medicine and the pharmaceutical industry (Strobel 2003). In the context of emerging health issues, such as novel/drug-resistant pathogens, among others, investigations into endophytic natural products have been played a pivotal role in the global fight against these ailments (Petersen et al. 2004; Cragg et al. 2009). The search for safer and novel natural products is important and can be achieved by selecting the biological resources from a unique environment of extreme age specific to interesting endemic locations or having ethanobotanical uses (Staniek et al. 2008). The northwestern Himalayas is a region that is endowed with unexplored microbial biodiversity. The forests of Bhaderwah, also referred to as “mini Kashmir”, have not been well studied, and the endophytic population of this region remains largely unexplored. The abundance of natural springs, brooks and mountains in this region influence the plant community.
Viola odorata Linn. (Violaceae), commonly called sweet violet or Banafsha, is a medicinal herb native to Europe, Asia, North America and Australia. In India, it grows in Kashmir, mini Kashmir and other parts of the western Himalayas at altitudes ranging from 1500 to 1800 m a.s.l. It is a hardy and annual/perennial herb/shrub that occurs in wild places exposed to sunlight (Erhatic et al. 2010). In traditional medicine, Banafsha has been used as a cure for a variety of skin and respiratory ailments (common cold, congestion, coughing and sore throat), insomnia, anxiety, low blood pressure, headache and cancer pains (Kapoor 1990; Keville 1991; Duke et al. 2002; Kermani and Soroush 2008; Siddiqi et al. 2012; Hamedi et al. 2013). Active constituents of V. odorata have been identified as alkaloid, tannins, phenolics, coumarins, flavonoids, glycoside, saponins, methyl saicylate, mucilage and vitamin C (Siddiqi et al. 2012). The plant has been reported to possess antibacterial, antifungal, antioxidant, antitumor, diuretic, laxative, analgesic, antihypertensive, antidyslipidemic anti-inflammatory, antipyretic, sedative, anthelmintic and mosquito-repellant activities (Khattak et al. 1985; Koochek et al. 2003; Svangård et al. 2004; Amer and Mehlhorn 2006; Colgrave et al. 2008; Vishal et al. 2009; Ebrahimzadeh et al. 2010; Akhbari et al. 2012; Barkatullah Ibrar et al. 2012; Alireza and Ali 2013; Zarrabi et al. 2013).
In the study reported here we focused on the diversity, distribution and phylogeny of the endophytic community associated with V. odorata endemic to the forests of Bhaderwah and assessed this community as producers of antimicrobials, antioxidants and industrially important enzymes.
Material and methods
Isolation of endophytes
Plants of V. odorata were collected during March–April 2014 from the forests of Bhaderwah (mini Kashmir 33.04°N 75.40°E; 1613 m a.s.l.) and identified based on taxonomic features. For the isolation of endophytes, we first carefully excised and then cleaned the roots, leaf nodes and leaves of the plants according to Strobel and Daisy (2003) and Katoch et al. (2014) with slight modification. Clean tissues were serially sterilized in solutions of 70% ethanol, followed by 1.0% sodium hypochlorite (v/v) and then by 70% ethanol, for 1 min/solution, with two final rinses in sterile deionized water; they were then blotted dry and cut into 1-cm2 pieces. The pieces were placed on water and potato dextrose agar (PDA) plates containing streptomycin (250 μg/mL). At the same time, the water used for washing the tissues (100 μL) was also plated on PDA plates to confirm the effectiveness of the surface sterilization protocol. All plates were wrapped in Parafilm and incubated at 25 ± 2 °C, and observed daily. The fringes of fungal mycelia growing out from the tissues were subcultured on new PDA plates. These endophytes were deposited in the RN Chopra Microbial Repository, IIIM.
Identification and phylogenetic evaluation of endophytic fungi
The endophytes were identified based on morpho-cultural characteristics and by internal transcribed spacer (ITS)-based rDNA sequencing. Genomic DNA of the endophytes was extracted from the in vitro grown biomass (Raeder and Broda 1985). The ITS1–5.8S–ITS2 region spanning 500–600 bp was amplified with ITS1 and ITS4 universal primers (White et al. 1990). The PCR assay was run in a total volume of 50 μL containing DNA (1–10 ng), 1× PCR buffer (with 15 mM MgCl2), each dNTP (200 mM), both primers (10 pmol; Integrated DNA Technologies, Leuven, Belgium) and 1 U Taq DNA polymerase (Promega, Madison, WI). Cycling parameters were 5 min at 94 °C, followed by 30 cycles of 94 °C for 30 s, 55 °C for 1 min and 72 °C for 1 min, with a final extension for 10 min at 72 °C. The PCR product [Electronic Supplementary Material (ESM) Fig. S1] was purified using a gel extraction kit (Qiagen, Hilden, Germany), and the sequencing reaction was set up in a volume containing 10 μL:40–60 ng of purified PCR product, 3.2 pmol forward/reserve primer and Big Dye Terminator sequencing mix 8 μL (v. 3.1; Applied Biosystems, Foster City, CA). Samples were sequenced on an automated sequencing system (Applied Biosystems). Resultant sequences (KX621956–KX621982) were submitted to Genbank and blasted against the nucleotide database using the BLASTn tool of the U.S. National Centre for Biotechnology Information for final identification of endophytes (Altschul et al. 1997). For phylogenetic evaluation, endophytic ITS DNA sequences identified in this study and downloaded sequences of their nearest neighbors were analyzed using the tools of MEGA4 software (Tamura et al. 2007).
Fungal diversity evaluation
To evaluate the endophytic fungal diversity associated with V. odorata, we calculated different α and β indices, such as Menhinick’s index (D mn ), Camargo’s index (1/D mn) or species richness, Fisher’s log series index (α), Simpson’s Dominance index (D), Simpson’s diversity index (SDI; 1 − D), the Shannon diversity index (H′), and Margalef’s richness (D mg) (Hoffman et al. 2008; Tao et al. 2008; Kusari et al. 2013). The similarity indices for endophytic assemblages among tested tissues were also evaluated using Sorensen’s (QS) and Jaccard’s (Jc) indices using the equations QS = 2a/(2a + b + c) and Jc = a/(a + b + c), respectively, where a is the number of common fungal species found in endophytic populations of two different tissues, and b and c are the number of endophytic fungal species specific to tissues under comparison (Osono and Mori 2004).
Fermentation and extraction
Endophytes were cultured by inoculating two actively growing fungal blocks in potato dextrose broth (400 mL) and incubating the cultures at 27 ± 2 °C and 180 rpm (New Brunswick Scientific Co., Inc., Enfield, CT). After 10 days, each culture was blended thoroughly in 20% methanol and extracted with one volume of methylene chloride [high-performance liquid chromatography (HPLC) grade]. The process was repeated four times. Extracts were vacuum dried.
Antimicrobial activity
Pathogens, namely Bacillus subtilis (MTCC No. 121), Staphylococcus aureus (MTCC No. 737), Salmonella typhimurium (MTCC No. 98), Pseudomonas aeruginosa (MTCC No. 424), Escherichia coli (MTCC No. 118), Klebsiella pneumoniae (MTCC No. 109) and Candida albicans (MTCC No. 183), were procured from the Microbial Type Culture Collection (MTCC), Chandigarh (India). All were grown on Muller Hinton agar, with one exception—C. albicans was grown on yeast extract peptone dextrose agar.
The antibacterial activity was studied against the test organism by the agar disc diffusion and microdilution assay (Rios et al. 1988; Devaraju and Sreedharamurthy 2011). Streptomycin and amphotericin B were used as positive controls for bacterial pathogens (both Gram-positive and Gram-negative microorganisms) and for C. albicans, respectively.
Bacterial strains were inoculated into Muller Hinton broth (HiMedia Biosciences, Mumbai, India) and incubated at 37 °C in a shaker (200 rpm) for 16 h. The cells were quantified according to McFarland standard turbidity [with 0.5 = 1.5 × 108 colony forming units (CFU)/mL] and ultimately diluted to 1.5 × 105 CFU/mL for all pathogens.
Agar disc diffusion assay
Discs cut out of 10-day-old endophytic cultures (disc diameter 6 mm) were loaded into wells prepared on Muller Hinton agar plates (diameter 90 mm) containing 20 mL medium. A 100-μL aliquot of cell suspension (1.5 × 105 CFU/mL) of the test organism was then spread on the agar plates and the plates incubated at 37 °C. Antibacterial activities of endophytes were recorded as the zones of inhibition (ZI, in millimeters) produced on each plate. Endophytes were considered to possess effective antibacterial activity when the ZI was ≥18 mm (Guimaraes et al. 2008).
Microdilution assay
Different dilutions (1–100 μg/mL) were prepared from the stock solutions of fungal extract (10 mg/mL) and antibiotic (1 mg/mL). A 150-μL aliquot of each dilution of fungal extract and antibiotic was mixed with 50 μL of media containing 4 × 104 bacterial cells (diluted from the stock solution of 1.5 × 108 CFU/mL). Appropriate negative (0.5% dimethyl sulfoxide) and blank controls (virgin media) were used. A 96-well plate was incubated overnight at 37 °C in a incubator shaker with 150 rpm. Activities were expressed in terms of minimum inhibitory concentration (MIC)/minimum bactericidal concentration (MBC).
Quantification of penicillin G by liquid chromatography-electrospray ionization–tandem mass spectrometry
Penicillin G in endophytic extracts was quantified by liquid chromatography-mass spectrometry.
Preparation of stock solutions of standard compounds
A stock solution of penicillin G (1.0 mg/mL) was prepared in HPLC grade methanol. Standard working solutions were then obtained by mixing and making appropriate dilutions of stock solutions using the same solvent. The concentration utilized for the preparation of a five-point calibration curve ranged between 3.12 and 50 ng/mL. The standard solutions were filtered through a 0.1 μ polytetrafluoroethylene disposal filter (Whatman; GE Healthcare Life Sciences, Chicago, IL) and injected directly. The stock and working solutions were stored at 4 °C.
Chromatography and LC-electrospray ionization–tandem MS conditions
The chromatography separation was performed on a Purospher® STAR RP18 endcapped column (50 × 2.1 mm) packed with 3-μm particles. The mobile phase consisted 10 mM ammonium formate pH 3.5 (A) and acetonitrile (B). An isocratic (50:50%) elution was used over 3 min. The flow rate was 0.3 mL/min. The injection volume was 10 μL and the column temperature was 25 °C. Prior to construction of the calibration curve, three blank injections were run to check the noise level of the system. The calibration equation of penicillin G was obtained by plotting the LC-MS peak area (y) versus the concentration (x, mg/mL) and found as y = 260.632× + 0 (R 2 = 0.999). The equation showed very good linearity over the range. A precursor ion scan experiment on penicillin G also confirmed the origin of daughter ions from the same molecular ion, thereby confirming their presence in the sample. All quantification protocols were performed in triplicate.
Antioxidant activity and phenolics and flavonoid content analysis
Antioxidant activity
The antioxidant activity of each isolated endophyte was evaluated by the 2,2-diphenyl-1-picrylhydrazyl (DPPH) assay. A 100-μL aliquot of fungal extract (3.125–200 μg/mL) was added to a 96-well plate, followed by the addition of 100 μL of DPPH solution (0.2 mM in HPLC grade ethanol) to each well (both test and control wells) and the plate incubated at room temperature in the dark. After 30 min, absorbance was measured at 517 nm. Ascorbic acid and DMSO were used as the positive and negative control, respectively. The free radical scavenging percentage was calculated. The IC50 value (50 % inhibition of activity) was interpolated by plotting a linear regression curve:
Total phenolic content
The total phenolic content in each extract was determined by the Folin–Ciocalteu method as described by Cui et al. (2015) with minor modification. A stock solution of extract (10 mg/mL) was made in methanol, and 100 μL of diluted extract was mixed thoroughly with 500 μL of Folin–Ciocalteu reagent (1:10 diluted with distilled water) and 400 μL of sodium carbonate solution (7.5%). The mixture was incubated in the dark for 30 min at room temperature, following which absorbance was measured at 765 nm using a spectrophotometer. The total phenolic content was calculated using the gallic acid calibration curve from the equation y = 0.030× + 0.118 (R 2 = 0.973), where y is absorbance and x is concentration (μg/mL). Total phenolic content was expressed as micrograms/milligram gallic acid equivalent dry weight.
Total flavonoid content
Total flavonoid content was determined using the aluminum chloride colorimetric method described by Zhao et al. (2014) with slight modification. A 400-μL aliquot of crude extract (10 mg/mL) was mixed with a methanolic AlCl3⋅6H2O solution and incubated for 5 min in the dark. The absorbance was measured at 430 nm, and total flavonoid content was calculated using the quercetin calibration curve from the equation y = 0.010× + 0.002 (R 2 = 0.995), where y is absorbance and x is concentration (μg/mL). Total flavonoid content was expressed as μg/mg quercetin equivalent dry.
Enzyme-producing potential
The enzyme production potential of endophyte was evaluated by the agar disc diffusion assay (Hankin and Anagnostakis 1975). For each enzyme, 1% specific substrate was added to PDA media (starch for amylase; carboxyl methyl cellulose for cellulase; skimmed milk for protease; gluten for glutenase). For estimating the lipase activity, 98 mL of 50 mM Tris HCl, pH 6.8, and 1.2 g agar was autoclaved. In 2 mL of autoclaved Tris HCl, 300 μL of tributyrin and 30 μL of Tween 20 were added and mixed with the Tris-agar and poured over the plates. Wells were prepared in the plates using a sterilized stainless steel cork borer, and the wells then loaded with a 6-mm-diameter disc containing 10-day-old endophytic cultures. The plates were incubated at 27 ± 2 °C for 72–96 h. For amylase/cellulase, plates were stained with Gram’s iodine/Congo red (2%) for 5 min. The enzymatic activity was expressed as the average diameter of the degradation halo (ZC). The experiments were repeated three times.
Statistical analysis
Antimicrobial and antioxidant activity data were assessed with analysis of variance and Tukey’s post hoc analysis using GraphPad Prism software (GraphPad Software, Inc, La Jolla, CA).
Results
Endophytic fungi associated with V. odorata
Twenty-seven endophytes from ten different genera were isolated from V. odorata (Table 1). The maximum number of endophytes (14 isolates) was found in roots followed by leaves (7 isolates) and leaf nodes (6 isolates). The majority of the endophytic fungi belonged to phylum Ascomycota, with the exception VOLF5 (Peniophora sp.), which belongs to Basidiomycota. These endophytes belong to four different classes: Sordariomycetes (59.25%), Eurotiomycetes (33.25%), Dothideomycetes (3.75%) and Agaricomycetes (3.75%). The most dominant class observed was Sordariomycetes, represented by the orders Trichosphaeriales, Hypocreales, Glomerellales and Xylariales, while class Eurotiomycetes was represented by the order Eurotiales. The fungal endophytes belonging to classes Sordariomycetes and Eurotiomycetes were distributed in all plant tissues, whereas those belonging to class Dothideomycetes were found in leaf node tissue and were represented by the order Capnodiales. Endophytes belonging to class Agaricomycetes were restricted to leaves only. Colletotrichum spp. (25.9%) showed the highest isolation frequency and were distributed in all plant tissues, followed by Fusarium spp. (22.2%), which were restricted to the roots. Endophytes specifically isolated from the leaves were Colletotrichum trifolii, Cladosporium tenuissimum, Aspergillus japonicus and Peniophora sp. Daldinia eschscholtzii, Aspergillus niger and Colletotrichum siamense were found to be specific to leaf nodes, and roots harbored Nigrospora sp., Fusarium nematophilum, F. solani, Colletotrichum truncatum, Nectria haematococca, Aspergillus awamori, Fusarium sp., F. oxysporum and Paecilomyces tenuis.
Phylogenetic evaluation
The phylogenetic tree provided a more detailed picture of the diverse taxonomic affinities among the endophytic isolates recovered from various tissues of V. odorata L., reflecting their evolutionary history (Fig. 1). The endophytic fungi were grouped into four different clusters based on ITS sequences. Each cluster belongs to separate class, i.e. Sordariomycetes, Eurotiomycetes, Dothideomycetes and Agaricomycetes. Of the sequences in cluster I, 43% ware related to Colletotrichum spp. (VOR7, VOR11, VOR12, VOLN4, VOLN5, VOLF2 and VOLF3) and another 43% are related to Fusarium spp. (VOR3, VOR5, VOR6, VOR10, VOR15, VOR16 and VOR18). Other species included in this cluster are Nigrospora sp. (VOR1) and D. eschscholtzii (VOLN2).
Cluster II contains a single isolate of Cladosporium tenuissimum (VOLF7), while cluster III comprises endophytes from class Eurotiomycetes, including Aspergillus spp. (VOR14, VOLN1, VOLN3, VOLF4 and VOLF6), Penicillium spp. (VOR4, VOLN7 and VOLF1) and P. tenuis (VOR17). In cluster IV, there was a single isolate VOLF5 (Peniophora sp.) belonging to phylum Basidiomycota.
Fungal diversity analysis
The diversity of the endophytic fungal population isolated from different tissues was evaluated using various α-diversity indices (Table 2). The Simpson Dominance index was highest (0.1667) in leaf node tissue followed by (0.1429) leaf and root tissues (0.1122), whereas Simpson’s diversity index was highest in roots (0.8878) followed by leaf (0.8571) and leaf node tissues (0.8333). The Whittaker diversity index was found to be 1.5. Species evenness was more in leaves and leaf nodes than in roots. The Shannon effective number of species was found to be ten for the root, six for the leaf node and seven for leaves. Based on these diversity indices, roots were assessed to host the highest biodiversity, followed by the leaf and leaf node. Higher similarity indices between leaves and leaf nodes depict that the endophytic community of these tissues is more similar (Table 2).
Antimicrobial activity
About 89% of extracts showed antimicrobial activity against the tested pathogens, with the ZI ranging from 20 to 54 mm (Table 3; ESM Fig. S2). In total, 13 (48%), six (22%), 13 (48%), 16 (59%), four (15%) and 15 (55%) extracts exhibited significant antimicrobial activity against Esherichia coli, Klebsiella pneumoniae, Staphylococcus aureus, Pseudomonas aeruginosa, Salmonella typhimurium and Bacillus subtilis, respectively. Only three extracts VOLN5 (C. siamense), VOLF4 (Aspergillus sp.), VOLF6 (A. japonicas) were active against Candida albicans, with ZI of 24–32 mm. Extracts of VOLN5 (C. siamense) displayed a ZI of 24–54 mm against all the tested human pathogens, including C. albicans. Endophytes isolated from root did not display any activity against S. typhimurium and C. albicans.
In the microdilution assay, 15% of endophytes showed antimicrobial activity with a MIC of >10 μg/mL (Table 3). The VOR16 (F. oxysporum) extract showed significant antimicrobial activity against E. coli, K. pneumoniae and S. typhimurium, with an MIC of 0.78, 0.78 and 1.56 μg/mL, respectively, while VOR12 (Colletotrichum destructivum) was active against B. subtilis. Two extracts, VOR18 (F. nematophilum) and VOLN1 (Aspergillus sp.) were active against C. albicans. Endophytes isolated from leaves did not show any antimicrobial activity against any of the tested pathogen at a MIC of <100 μg/mL.
To identify the constituent responsible for antimicrobial activity, we measured the penicillin G content in bioactive endophytic extracts by LC–MS, and the results are shown in ESM Table S1 and ESM Figs. S3 andS4). Among the tested extracts, the highest penicillin content was observed in endophyte VOR18 (45.7 ng/mg) followed by VOR16 (42.068 ng/mg), VOLN1 (22.3 ng/mg) and VOR12 (not detected). The total penicillin G were in the order of VOR18 > VOR16 > VOLN1 (highest to lowest).
Antioxidant activity
Four extracts, namely VOR5 (F. nematophilum), VOR16 (F. oxysporum), VOLN2 (D. eschscholtzii) and VOLF4 (Aspergillus sp.) showed antioxidant activity, with IC50 values ranging from 17.8 to 50 μg/mL (Table 4). VOLF4 (Aspergillus sp.) extract had the best antioxidant activity (IC50 value 17.8 μg/mL), while VOLN2 (D. eschscholtzii) extract showed the lowest antioxidant activity (IC50 value 50 μg/mL).
Total phenolics and flavonoid content present in endophytic extracts showing significant antioxidant activity were determined spectrophotometrically, and the results are shown in Table 4 (ESM Figs. S5, S6). Among the tested extracts, the highest phenolic content was observed in endophyte VOLN2 (120.95 μg/mg) followed by VOLF4 (92.5 μg/mg), VOR16 (41.06 μg/mg) and VOR5 (19.42 μg/mg), respectively. Total flavonoids content were in the order VOLF4 > VOLN2 > VOR16 > VOR5.
Extracellular enzyme production
About 17 (63%) endophytes produced one or more enzyme, with a ZC ranging from 20 to 48 mm (Table 5; EMS Fig. S7). Of the endophytes assessed, 33, 7, 26, 37 and 22% were found to be producers of significant levels of cellulase, lipase, amylase, protease and glutenase enzymes, respectively. The highest ZC (48 mm) was reported in VOLN5 (C. siamense) for protease production. Of 27 endophytic fungi, only VOR5 (F. nematophilum) was found to be a producer of cellulase, glutenase, amylase and protease.
Discussion
Several medicinal plants have been explored for the isolation of endophytic fungi (Kaul et al. 2012). We report here the isolation and characterization of endophytic fungi from tissues of V. odorata. There were striking differences in the endophytic community of V. odorata from the forests of Bhaderwah (33.04°N 75.40°E) (our study) and that from Himachal Pradesh (India) (31.7082°N, 76.9314°E) (Gautam 2013). In our study, most of the endophytic fungi belong to phylum Ascomycota, with the exception of VOLF5 (Peniophora sp.) which belongs to phylum Basidiomycota. The endophytic fungi isolated from Himachal Pradesh (India) belong to the Ascomycota and Zygomycota phyla (Gautam 2013). The endophytes from our study belong to classes Sordariomycetes, Dothideomycetes, Agaricomycetes and Eurotiomycetes, while those from Himachal Pradesh (India) have been reported to belong to classes Dothideomycetes and Saccharomycetes. Aspergillus and Cladosporium endophytes were common in both studies; however, some endophytes, namely C. trifolii, C. destructivum, Peniophora sp. and Penicillium sp., were identified from V. odorata in our study for the first time. Of these endophytes, C. trifolii was reported for the first time as an endophyte. These differences suggest that ecological parameters significantly influence the community of endophytes present in a plant. Similarly, change in the endophytic assemblages due to altitude has also been observed by Hashizume et al. (2008). These endophytes help the host to adapt to a particular niche (Vega et al. 2010).
It is well known that endophytes help the plant to adapt to its ecological niche. Fusarium nematophilum, considered to be a nematode-associated fungus (Nirenberg and Hagedorn 2008), is reported here for the first time from V. odorata as an endophyte. Isolation of this endophyte might suggest its involvement in protecting V. odorata plants from root galls typical of root-knot nematode injury caused by Meloidogyne javanica (Martin 1958).
Further, variation in the endophytic community was also observed in the root, leaf node and leaf tissues of V. odorata. Interestingly, some of the endophytes found in one tissue did not colonize in other tissues, suggesting that distinct micro-environments of tissues are responsible for structuring their micro-biota. Thus, tissue specificity was evident among the endophytes of V. odorata.
The antimicrobial potential of the endophytes was tested using an agar disc diffusion assay and a micro-dilution assay. Using the agar disc diffusion assay, we found that 89% of extracts were active, with a ZI ranging from 20 to 54 mm. Similar the report of Devaraju and Sreedharamurthy (2011), we found that Gram-positive bacteria were more susceptible to endophytes than Gram-negative bacteria. In the micro-dilution assay, 15% of endophytes showed antimicrobial activity, with a MIC of >10 μg/mL. Similarly, Ramos et al. (2010) reported that extracts of endophytes, such as Papulaspora immerse and Arthrinium arundinis, inhibited the tested pathogens, with a MIC ranging from 90 to 280 μg/mL, while extracts of bacterial endophytes isolated from Aloe vera displayed antimicrobial activity with a MIC/MBC of 0.625–20 mg/mL. These values are quite low as compared to those determined in our study (Akinsanya et al. (2015).
Antimicrobial activity of one of its endophytic [VOR16 (F. oxysporum)] extract against K. pneumoniae (MIC 0.78 μg/mL) might support the traditional use (to treat cough) of this medicinal plant by producing secondary metabolites through cross-talk between endophyte and host.
To determine the constituent responsible for antimicrobial activity, penicillin G in extracts of bioactive endophytes was estimated by LC–MS. The penicillin G content in extract of the endophytes ranged from 0 to 45.7 ng/mg. For functional activity, it should range between 275 and 1150 ng/mg (calculated with the MICs of penicillin G against different human pathogens shown in Table 4). This leads to the conclusion that the antimicrobial activity in the endophytes isolated in our study is due to secondary metabolite(s) other than penicillin G.
Compounds like penta-ketide (CR377: 2-methylbutyraldehyde-substituted-α-pyrone) and beauvericin, both isolated from endophytic Fusarium spp., have been found to be active against C. albicans, and methicillin-resistant S. aureus, respectively (Sean and Jon 2000; Wang et al. 2011). In our study, VOR18 (F. nematophilum) was found to be active against C. albicans but as per natural product library, no molecule is known from this species, suggesting further study is needed to isolate the bioactive molecule(s).
Some endophytes (15%) also exhibited potent antioxidant activity. Similar to Li et al. (2015), we found that Fusarium spp. (VOR5 F. nematophilum; VOR16 F. oxysporum) showed antioxidant activity and that Aspergillus sp. (VOLF4) showed the highest antioxidant activity, as reported by Yadav et al. (2014) and Khiralla et al. (2015). Previous researchers found that phenolics and flavonoids were responsible for antioxidant potential (Ravindran et al. 2012); moreover, presence of higher amount of phenolics and flavonoid content is directly related to antioxidant potential (Yadav et al. 2014). In our study, extract VOLF4 had both a higher amount of total flavonoid content and showed strong antioxidant activity, with an IC50 of 17.8 μg/mL. There was no correlation between phenolics content and antioxidant potential. Similarly, extract VOR5 contained the least amount of phenolic and flavonoid contents but showed moderate antioxidant potential, with an IC50 value of 22.7 μg/mL, possibly due to involvement of secondary metabolites other than phenolics and flavonoids, such as nitrous compounds, caroteonids and many unidentified compounds (Velioglu et al. 1998; Mahboubi et al. 2013).
The results of our study and of earlier ones indicate that the endophytes have the capability to produce enzymes (Bischoff et al. 2009; Bezerra et al. 2012). Basically, the production of enzymes from an endophyte is associated with its adaption and adaption of the host to that particular environment. Similarly, the production of cellulase and protease enzymes from VOR5 (F. nematophilum) is thought to be responsible for biocontrol potential, while amylases and glutenases may be associated with adaption under stress conditions.
In the study reported here, we isolated novel endophytes, such as Fusarium nematophilum, Collectotrichum trifolii, C. destructivum, C. siamense and Peniophora sp. from V. odorata for the first time. Of the endophytes isolated, Collectotrichum trifolii is reported for the first time as an endophyte. It is evident from the study that the roots hosted the highest endophyte biodiversity. The isolated endophytes exhibited antibacterial, antioxidant activity and enzyme-producing potential. Antimicrobial activity may be due to some novel secondary metabolite other than penicillin G, while antioxidant activity may be due to the high flavonoid content. Such studies as the one reported here may facilitate the management of such plants under different geographical locations, with a focus on their ex situ conservation, thereby facilitating bioprospecting of potential bioactive molecules and enzymes from endophytes for industrial purposes.
References
Akhbari M, Batooli H, Kashi FJ (2012) Composition of essential oil and biological activity of extracts of V. odorata L. from central Iran. Nat Prod Res 26:802–809. doi:10.1080/14786419.2011.558013
Akinsanya MA, Goh JK, Lim SP, Ting ASY (2015) Diversity, antimicrobial and antioxidant activities of culturable bacterial endophyte communities in Aloe vera. FEMS Microbiol Lett 362:fnv184. doi:10.1093/femsle/fnv184
Alireza M, Ali R (2013) Evaluation of sedative and pre-anesthetic effects of V. odorata L. extract compared with diazepam in rats. Bull Env Pharmacol Life Sci 2:125–131
Altschul SF, Madden TL, Schaffer AA, Zhang J, Zhang Z, Miller W, Lipman DJ (1997) Gapped BLAST and PSI-BLAST: a new generation of protein database search programs. Nucleic Acids Res 25:3389–3402. doi:10.1093/nar/25.17.3389
Amer A, Mehlhorn H (2006) Repellency effect of forty-one essential oils against aedes, anopheles and culex mosquitoes. Parasitol Res 99:478–490. doi:10.1007/s00436-006-0184-1
Barkatullah Ibrar M, Ali N, Muhammad N, Meryam E (2012) In vitro pharmacological study and preliminary phytochemical profile of V. canescens wall. Ex Roxb. Afr J Pharm Pharmacol 6:1142–1146
Bezerra JD, Santos MG, Svedese VM, Lima DM, Fernandes MJ, Paiva LM, Souza-Motta CM (2012) Richness of endophytic fungi isolated from Opuntia ficus-indica mill. (Cactaceae) and preliminary screening for enzyme production. World J Microbiol Biotechnol 28:1989–1995. doi:10.1007/s11274-011-1001-2
Bischoff KM, Wicklow DT, Jordan DB, De Rezende ST, Liu SQ, Hughes SR, Rich JO (2009) Extracellular hemicellulolytic enzymes from the maize endophyte Acremonium zeae. Curr Microbiol 58:499–503. doi:10.1007/s00284-008-9353-z
Brundrett MC (2006) Understanding the roles of multifunctional mycorrhizal and endophytic fungi. In: Schulz BJE, Boyle CJC, Sieber TN (eds) Microbial root endophytes. Springer, Berlin, pp 281–293
Clay K, Holah J (1999) Fungal endophyte symbiosis and plant diversity in successional fields. Science 285:1742–1745. doi:10.1126/science.285.5434.1742
Colgrave ML, Kotze AC, Ireland DC, Wang CK, Craik DJ (2008) The anthelmintic activity of the cyclotides: natural variants with enhanced activity. Chembiochem 9:1939–1945. doi:10.1002/cbic.200800174
Cragg GM, Grothaus PG, Newman DJ (2009) Impact of natural products on developing new anti-cancer agents. Chem Rev 109:3012–3043. doi:10.1021/cr900019j
Cui JL, Guo TT, Ren ZX, Zhang NS, Wang ML (2015) Diversity and antioxidant activity of culturable endophytic fungi from alpine plants of Rhodiola crenulata, R. angusta, and R. sachalinensis. PLoS One 13:e0118204
Devaraju R, Sreedharamurthy S (2011) Endophytic Mycoflora of Mirabilis jalapa L. and studies on antimicrobial activity of its endophytic Fusarium sp. Asian J Exp Biol Sci 2:75–79
Duke JA, Bogenschutz-Godwin MJ, Ducelliar J, Duke PAK (2002) Sweet violet (V. odorata L.), handbook of medicinal herbs, 2nd edn. CRC Press, Boca Raton,
Ebrahimzadeh MA, Nabavi SM, Nabavi SF, Bahramian F, Bekhradnia AR (2010) Antioxidant and free radical scavenging activity of H. officinalis L. Var. Angustifolius, V. odorata, B. hyrcana and C. speciosum. Pak J Pharma Sci 23:29–34
Erhatic R, Vukobratovic M, Volf TP, Zidovec V (2010) Morphological and chemical properties of selected sweet violet populations. JCEA 11:55–64
Gautam AK (2013) Diversity of fungal endophytes in some medicinal plants of Himachal Pradesh, India. Arch Phytopathol Plant Protect 47:537–544. doi:10.1080/03235408.2013.813678
Guimaraes DO, Borges WS, Kawano CY, Ribeiro PH, Goldman GH, Nomizo A, Thiemann OH, Oliva G, Lopes NP, Pupo MT (2008) Biological activities from extracts of endophytic fungi isolated from Viguiera arenaria and Tithonia diversifolia. FEMS Immunol Med Microbiol 52:134–144. doi:10.1111/j.1574-695X.2007.00354.x
Hamedi A, Zarshenas MM, Sohrabpour M, Zargaran A (2013) Herbal medicinal oils in traditional Persian medicine. Pharm Biol 51:1208–1218. doi:10.3109/13880209.2013.777462
Hankin L, Anagnostakis SL (1975) The use of solid media for detection of enzyme production by fungi. Mycologia 67:597–607. doi:10.2307/3758395
Hashizume Y, Sahashi N, Fukuda K (2008) The influence of altitude on endophytic mycobiota in Quercus acuta leaves collected in two areas 1000 km apart. Forest Pathol 38:218–226. doi:10.1111/j.1439-0329.2008.00547.x
Hoffman M, Gunatilaka M, Ong J, Shimabukuro M, Arnold AE (2008) Molecular analysis reveals a distinctive fungal endophyte community associated with foliage of Montane oaks in southeastern Arizona. J Ariz Nev Acad Sci 40:91–100. doi:10.2181/1533-6085(2008)40[91:MARADF]2.0.CO;2
Kapoor LD (1990) V. odorata L. handbook of Ayurvedic medicinal plants. CRC Press, Boca Raton
Katoch M, Singh G, Sharma S, Gupta N, Sangwan PL, Saxena AK (2014) Cytotoxic and antimicrobial activities of endophytic fungi isolated from Bacopa monnieri (L.) Pennell (Scrophulariaceae). BMC Compl Altern Med 14:52. doi:10.1186/1472-6882-14-52
Kaul S, Gupta S, Ahmed M, Dhar MK (2012) Endophytic fungi from medicinal plants: a treasure hunt for bioactive metabolites. Phytochem Rev 11:487–505. doi:10.1007/s11101-012-9260-9266
Kermani HR, Soroush Z (2008) Effect of long-term axial spinal unloading on vertebral body height in adult thoracolumbar spine. Eur Spine J 17:965–969. doi:10.1007/s00586-008-0669-y
Keville K (1991) V. odorata L. illustrated herb encyclopedia. Michael Friedman, New York
Khattak SG, Gilani SN, Ikram M (1985) Antipyretic studies on some indigenous Pakistani medicinal plants. J Ethnopharmacol 14:45–51. doi:10.1016/0378-8741(85)90027-3
Khiralla A, Mohamed I, Thomas J, Mignard B, Spina R, Yagi S, Mattar DL (2015) A pilot study of antioxidant potential of endophytic fungi from some Sudanese medicinal plants. Asian Pac J Trop Med 8:701–704. doi:10.1016/j.apjtm.2015.07.032
Koochek MH, Pipelzadeh MH, Mardani H (2003) The effectiveness of V. odorata in the prevention and treatment of formalin-induced lung damage in the rat. J Herbs Spices Med Plants 10:95–103. doi:10.1300/J044v10n02_11
Kusari P, Kusari S, Spiteller M, Kayser O (2013) Endophytic fungi harbored in Canniabis sativa L. diversity and potential as biocontrol agents against host plant specific phytopathogens. Fungal Divers 60:137–151. doi:10.1007/s13225-012-0216-3
Li YL, Xin XM, Chang ZY, Shi RJ, Miao ZM, Ding J, Hao GP (2015) The endophytic fungi of Salvia miltiorrhiza Bge.F. alba Are a potential source of natural antioxidants. Bot Stud 56:1–7. doi:10.1186/s40529-015-0086-6
Mahboubi M, Kazempour N, Nazar AR (2013) Total phenolic, total flavonoids, antioxidant and antimicrobial activities of Scrophularia striata Boiss extracts. Jundishapur J Nat Pharm Prod 8:15–19
Martin GC (1958) Root-knot nematodes (Meloidogyne spp.) in the Federation of Rhodesia and Nyasaland. Nematologica 3:332–349
Martins F, Pereira JA, Bota P, Bento A, Baptista P (2016) Fungal endophyte communities in above and below ground olive tree organs and the effect of season and geographical location on their structures. Fungal Ecol 20:193–201. doi:10.1016/j.funeco.2016.01. 005
Nirenberg H, Hagedorn G (2008) Fusarium nematophilum spec. nov—ein neuer Nematoden-assoziierter Pilz. Nachrichtenbl Deut Pflanzenschutzd 60:213–216
Omacini M, Chaneton EJ, Ghersa CM, Müller CB (2001) Symbiotic fungal endophytes control insect host-parasite interaction webs. Nature 409:78–81. doi:10.1038/35051070
Osono T, Mori A (2004) Distribution of phyllosphere fungi within the capacity of giant dogwood. Mycoscience 45:161–168
Petersen PJ, Wang TZ, Dushin RG, Bradford PA (2004) Comparative in vitro activities of AC98-6446, a novel semisynthetic glycopeptides derivative of the natural product mannopeptimycin alpha, and other antimicrobial agents against Gram-positive clinical isolates. Antimicrob Agents Chemoth 48:739–746. doi:10.1128/AAC.48.3.739-746.2004
Raeder U, Broda P (1985) Rapid preparation of DNA from filamentous fungi. Lett Appl Microbiol 1:17–20. doi:10.1111/j.1472-765X.1985.tb01479.x
Ramos HP, Braun GH, Pupo MT, Said S (2010) Antimicrobial activity from endophytic fungi Arthrinium state of Apiospora montagnei Sacc. And Papulaspora immerse. Braz Arch Biol Technol 53:629–632. doi:10.1590/S1516-89132010000300017
Ravindran C, Naveenan T, Varatharajan GR, Rajasabapathy R, Meena RM (2012) Antioxidants in mangrove plants and endophytic fungal associations. Bot Mar 55:269–279
Rios JL, Recio MC, Villar A (1988) Screening methods for natural products with antimicrobial activity: a review of the literature. J Ethnopharmacol 23:127–149. doi:10.1016/0378-8741(88)90001-3
Sean FB, Jon C (2000) CR377, a new pentaketide antifungal agent isolated from an endophytic fungus. J Nat Prod 3:1447–1448. doi:10.1021/np990568p
Siddiqi HS, Mehmood MH, Rehman NU, Gilani AH (2012) Studies on the antihypertensive and antidyslipidemic activities of V. odorata leaves extract. Lipids Health Dis 11:6. doi:10.1186/1476-511X-11-6
Staniek A, Woerdenbag HJ, Kayser O (2008) Endophytes: exploring biodiversity for the improvement of natural product based drug discovery. J Plant Interact 3:75–93. doi:10.1080/17429140801886293
Strobel GA (2003) Endophytes as sources of bioactive products. Microbes Infect 5:535–544. doi:10.1016/S1286-4579(03)00073-X
Strobel GA, Daisy B (2003) Bioprospecting for microbial endophytes and their natural products. Microbiol Mol Biol Rev 67:491–502. doi:10.1128/MMBR.67.4.491-502.2003
Svangård E, Göransson U, Hocaoglu Z, Gullbo J, Larsson R, Cleason P, Bohlin L (2004) Cytotoxic Cyclotides from V. tricolor. J Nat Prod 67:144–147. doi:10.1021/np03010 1l
Tamura K, Dudley J, Nei M, Kumar S (2007) MEGA4: molecular evolutionary genetics analysis (MEGA) software version 4.0. Mol Bio Evol 24:1596–1599. doi:10.1093/molbev/msm092
Tao G, Liu ZY, Hyde KD, Liu XZ, Yu XN (2008) Whole rDNA analysis reveals novel and endophytic fungi in Bletilla Ochracea (Orchidaceae). Fungal Divers 33:101–122
Vega FE, Simpkins A, Aime MC (2010) Fungal endophyte diversity in coffee plants from Colombia, Hawaii, Mexico and Puerto Rico. Fungal Ecol 3:122–138. doi:10.1016/j.funeco.2009.07.002
Velioglu YS, Mazza G, Gao L, Oomah BD (1998) Antioxidant activity and total phenolics in selected fruits, vegetables, and grain products. J Agric Food Chem 46:4113–4117
Vishal A, Parveen K, Pooja S, Kannappan N, Kumar S (2009) Diuretic, laxative and toxicity studies of V. odorata aerial parts. Pharmacol Online 1:739–748
Wang QX, Li SF, Zhao F, Dai HQ, Bao B, Ding R, Gao H, Zhang LX, Wen HA, Lu HW (2011) Chemical constituents from endophytic fungus F. oxysporum. Fitoterapia 82:777–781. doi:10.1016/j.fitote.2011.04.002
White TJ, Bruns T, Lee S, Taylor J (1990) Amplification and direct sequencing of fungal ribosomal RNA genes for phylogenetics. In: Innis M, Gelfand D, Sninsky J, White T (eds) PCR protocols: a guide to methods and applications. Academic Press, San Diego, pp 315–322
Yadav M, Yadav A, Yadav JP (2014) In vitro antioxidant activity and total phenolic content of endophytic fungi isolated from Eugenia jambolana lam. Asian Pac J Trop Med 7:S256–S261. doi:10.1016/S1995-7645(14)60242-X
Zarrabi M, Dalirfardouei R, Sepehrizade Z, Kermanshahi RK (2013) Comparison of the antimicrobial effects of semipurified cyclotides from Iranian V. odorata against some of plant and human pathogenic bacteria. J Appl Microb 115:367–375. doi:10.1111/jam.12251
Zhao J, Ma D, Luo M, Wang W, Zhao C, Zu Y, Fu Y, Wink M (2014) In vitro antioxidant activities and antioxidant enzyme activities in HepG2 cells and main active compounds of endophytic fungus from pigeon pea [Cajanus cajan (L.) Millsp.] Food Res Int 28:243–251
Acknowledgments
This article bears the Institutional Publication No. IIIM/2143/2017 GAP1182. We acknowledge the DBT, Govt. of India for financial assistance under sponsored project GAP1182 (BT/PR4669/PBD/17/784/2012) and Council of Scientific and Industrial Research (CSIR) for proving the platform for research.
Author information
Authors and Affiliations
Corresponding author
Ethics declarations
Disclosure
The authors declare no conflicts of interest. All the experiments undertaken in this study comply with the current laws of the country where they were performed.
Electronic supplementary material
ESM 1
(DOC 1029 kb)
Rights and permissions
About this article
Cite this article
Katoch, M., Singh, A., Singh, G. et al. Phylogeny, antimicrobial, antioxidant and enzyme-producing potential of fungal endophytes found in Viola odorata . Ann Microbiol 67, 529–540 (2017). https://doi.org/10.1007/s13213-017-1283-1
Received:
Accepted:
Published:
Issue Date:
DOI: https://doi.org/10.1007/s13213-017-1283-1